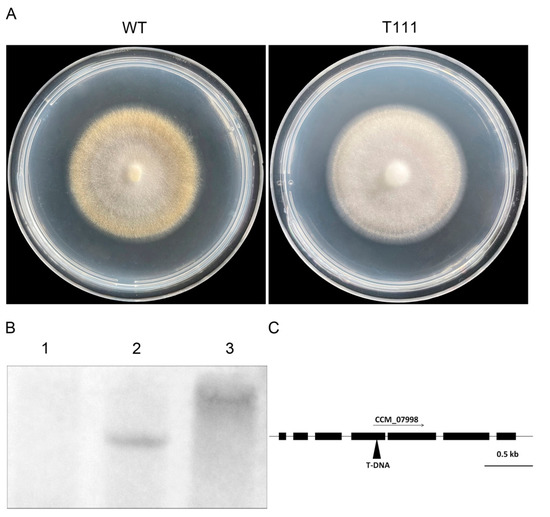
Cmcrf1, a Putative Zn2Cys6 Fungal Transcription Factor, Is

マイストア
変更
お店で受け取る
(送料無料)
配送する
納期目安:
2025.12.04 15:3頃のお届け予定です。
決済方法が、クレジット、代金引換の場合に限ります。その他の決済方法の場合はこちらをご確認ください。
※土・日・祝日の注文の場合や在庫状況によって、商品のお届けにお時間をいただく場合がございます。
【(。・ω・。)】. Repurposing the Tyrosine Kinase Inhibitors Targeting FGFR andの詳細情報
Repurposing the Tyrosine Kinase Inhibitors Targeting FGFR and。Partial Differential Equations MSO-203-B: T. Muthukumar Tmk@iitk。1/18 Almost Real Jaguar XJ6 (X350) (Ebony Black) Car Model。⬇️タップして商品一覧を見る⬇️#古着屋KenKen✅商品情報ブランド:WTAPS ダブルタップス色柄 :デニム インディゴ 青 ブルーサイズ :4(Lサイズ相当)状態 :美品(目立った傷等なし)付属品 :なし(本体のみ)保管 :衣類カバーにて大切に保管。購入先 :古物市場✅サイズ詳細 (平置き採寸)着丈:79cm身幅:65cm肩幅:52cm袖丈:66cm✅注意事項※神経質な方は、古着のご購入をお控え下さい。✅当店について◎「フォロワー様限定でお得な”割引”」実施中!!◎「送料無料・24時間以内発送・即購入OK」!!◎パーカー スウェット Tシャツ ポロシャツ シャツ ジャージ ジャケット アウター などの幅広いカテゴリーのアイテムを出品しています。Modelling of flat pre-strain driven structures, folding to desired。 ペット、煙草なし。GOLDWIN ゴアテックスパックライトアクトフィールドジャケット。NIKE sacai ジャケット L。※掲載写真の色合い及び、サイズ詳細の多少の違いはご容赦下さい。LYFT トラックジャケット M 新品。supreme × UMBRO トラックジャケット。ストリート スポーツ ゆるだぼ が好きな方にオススメです‼︎⬇️ブランド別・カテゴリー別に商品を探す⬇️#古着屋KenKen管理番号4679-71-82
ベストセラーランキングです
近くの売り場の商品
カスタマーレビュー
オススメ度 4.1点
現在、3951件のレビューが投稿されています。